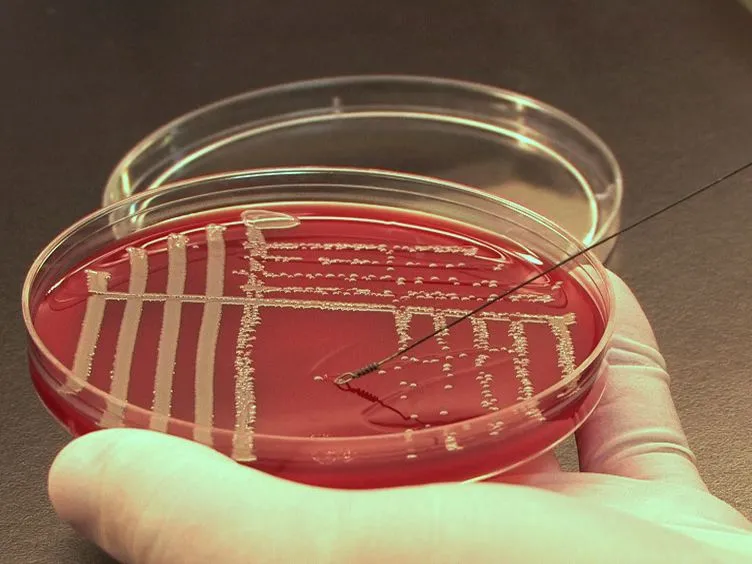
Fmiblog

Exploring the Methicillin-Resistant Staphylococcus Aureus (MRSA) Treatment Market Dynamics
Methicillin-Resistant Staphylococcus Aureus (MRSA) Treatment Market Analysis
The methicillin-resistant staphylococcus aureus (MRSA) treatment market is expanding significantly due to various factors influencing healthcare practices globally. This article explores essential dynamics shaping the market landscape.
Key Growth Drivers in the MRSA Treatment Market
- Rising Incidence of MRSA Infections: The increasing prevalence of MRSA infections highlights the urgent need for effective treatment options.
- Advancements in Pharmaceutical Research: Ongoing research breakthroughs are pivotal in developing innovative solutions for combatting MRSA.
- Shift Towards Personalized Medicine: Tailoring treatment approaches based on individual patient needs is becoming a trend.
Market Forecast and Trends
Forecasts indicate that the MRSA treatment market is poised for substantial growth, projected to reach USD 5.5 billion by 2030. This growth reflects both challenges and opportunities within the healthcare sector.
Innovations and Implications in MRSA Treatment
Innovative solutions and advanced technologies are expected to reshape the MRSA treatment landscape. Companies are increasingly investing in biotech advancements and new therapeutic mechanisms to face this persistent challenge in healthcare.
For more detailed insights on the growth trajectory of the methicillin-resistant staphylococcus aureus treatment market, please visit the source.
This article was prepared using information from open sources in accordance with the principles of Ethical Policy. The editorial team is not responsible for absolute accuracy, as it relies on data from the sources referenced.